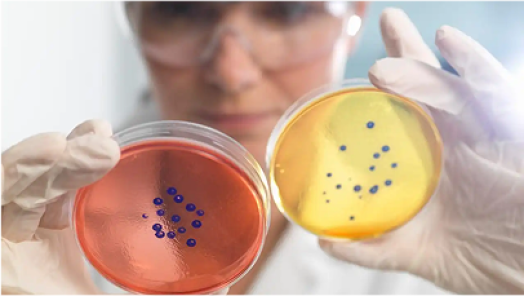

Качество жизни пациентов с псориазом проблемной локализации
У значительной доли пациентов, страдающих от псориаза, наблюдаются поражения кожи гениталий

У 62% пациентов псориаз встречается в области гениталий[1][2][3][4][5][6]

Симптомы генитального псориаза обычно развиваются в возрасте от 20 до 40 лет[7]

Различий в локализации псоратических поражений в области гениталий у мужчин и женщин не выявлено[2]
Развитие генитального или аногенитального псориаза обусловлено множеством факторов

Мужской пол[1][2][8]

Развитие псориаза в других зонах, тяжело поддающихся лечению (на ногтях, руках, ногах, волосистой части головы)[2]

Пожилой возраст[1][2]

Высокая оценка по индексу PASI / бόльшая площадь поражений (умеренная или тяжелая степень заболевания)[2][8]

Большая продолжительность заболевания[8]
Пациенты, страдающие от генитального псориаза, далеко не всегда обращаются к врачу, поэтому распространенность этого заболевания зачастую недооценивается
Зуд в области гениталий — наиболее типичный симптом, на который обращают внимание пациенты

Симптомы генитального псориаза оказывают влияние на повседневную жизнедеятельность пациента, социальные, психологические и трудовые аспекты его жизни
Источники:[10]
Стигматизация пациентов приводит к социальной изоляции и оказывает негативное влияние на психологическое здоровье и социальное функционирование

«Стигматизация — это ответ общества на угрозу, особенно если ее невозможно избежать или контролировать[11]»
«Аногенитальный псориаз сказывается на интимной жизни, и пациенту может казаться, что отношение к нему стало резко отрицательным[11]»
«Негативное влияние на психологическое состояние оказывает не столько площадь поражения, сколько стигматизация[12]»
Почти все пациенты, страдающие от псориаза, сталкиваются со стигматизацией из-за чего страдает качество жизни и частота обращения за медицинской помощью.
Источники:[13][14]
Генитальный псориаз отрицательно влияет на психологическое здоровье и социальное функционирование пациента

Источники:[3][9][10][11][12]

Источники:[4][7][9][10][11][15]
Вероятность сексуальной дисфункции у пациента, страдающего от псориаза, зависит от конкретной области поражения[3]

Доля людей, жалующихся на сексуальную дисфункцию, значительно выше среди пациентов с псориатическими поражениями в области живота, чем у пациентов без такой локализации[3]

Доля людей, жалующихся на сексуальную дисфункцию, также значительно выше среди пациентов с псориатическими поражениями в области поясницы, чем среди пациентов без такой локализации псориаза[3]

У пациентов с псориазом в области гениталий, ягодиц, живота или поясницы риск развития сексуальной дисфункции в 7,9 раза выше, чем у пациентов без псориатических поражений в этих областях[3]
Развитие псориаза в других областях — на груди, руках, бедрах, стопах, волосистой части кожи головы, ладонях и в области таза — также связано с возникновением сексуальной дисфункции,однако в этом случае связь между двумя заболеваниями не является статистически значимой
Краткое описание неудовлетворенных потребностей пациентов с генитальным псориазом[16]

Пациентам необходимы эффективные варианты терапии с хорошей переносимостью, которые cнижают выраженность генитальных поражений и улучшают качество жизни и сексуальное здоровье
Применение гуселькумаба приводит к постепенному улучшению значений PGA и индекса DLQI17 для аногенитальной области[17]
Оценка PGA в исследовании PERSIST у пациентов с аногенитальным псориазом при исходном PGA ≥ 2 балла

На неделе 28 у 84,3 % пациентов с аногенитальным псориазом отмечалось полное или почти полное разрешение симптомов.
Оценка PGA в исследовании PERSIST у пациентов с аногенитальным псориазом при исходном PGA ≥ 2 балла

Наличие аногенитального псориаза не влияло на качество жизни 52,5% пациентов на 28 неделе терапии препаратом ТРЕМФЕЯ.
Новые данные: псориаз генитальной области
Данные реальной практики по гуселькумабу: исследование GULLIVER (результаты промежуточного анализа данных)
В исследовании GULLIVER участвовали взрослые пациенты со значительным поражением кожи гениталий (sPGA ≥ 3)[18]

Более 7 из 10 пациентов добились полного / почти полного очищения кожи в области гениталий уже на неделе 12[18]

ДОБЕЙТЕСЬ ЗНАЧИТЕЛЬНОГО УМЕНЬШЕНИЯ ТЯЖЕСТИ СИМПТОМОВ В ОБЛАСТИ ГЕНИТАЛИЙ* ВМЕСТЕ С ПРЕПАРАТОМ ТРЕМФЕЯ[18]
Вам может быть интересно:

Узнайте, как меняется качество жизни пациентов в результате терапии препаратом Тремфея

Что если бы вы могли разорвать порочный круг рецидивов псориаза у своих пациентов?
Использованная литература
[1] Da Silva N et al. J Eur Acad Dermatol Venereol 2020;34:1010‒18
[2] Larsabal M et al. Br J Dermatol 2019;180:647‒56
[3] Molina-Leyva A et al. An Bras Dermatol 2015;90:338‒45
[4] Egeberg A et al. BMC Dermatol 2020;20:3
[5] Meeuwis K et al. J Dermatol Treat 2018;29:754‒60
[6] Meeuwis K et al. Dermatology 2012;224:271‒6
[7] Meeuwis K et al. J Eur Acad Dermatol Venereol 2010;24:1425–30
[8] da Silva N et al. PLoS One 2020;15:e0235091
[9] Cather JC et al. Dermatol Ther 2017;7:447‒61
[10] Yang EJ et al. Psoriasis (Auckl) 2018;8:41‒7
[11] Duarte GV et al. Psoriasis (Auckl) 2018;8:93‒9
[12] Kelly A, Ryan C. Am J Clin Dermatol 2019:doi:10.1007/s40257-019-00447-5
[13] Jankowiak B et al. Dermatology 2020;doi:10.1159/000510654
[14] Chen A et al. J Psoriasis Psoriatic Arth 2018;3:100‒6
[15] Schielein M et al. Acta Derm Venereol 2020;100:adv00151
[16] Kerdel F, Zaiac M. Dermatol Ther 2015;28:390‒403
[17] Gerdes S et al. J Dermatol 2021;doi:10.1111/1346-8138.16128
[18] Bonifati C, et al. Effectiveness and safety of guselkumab in patients with facial and/or genital psoriasis: interim analysis results at week 12 from the GULLIVER study. 2022 г.




